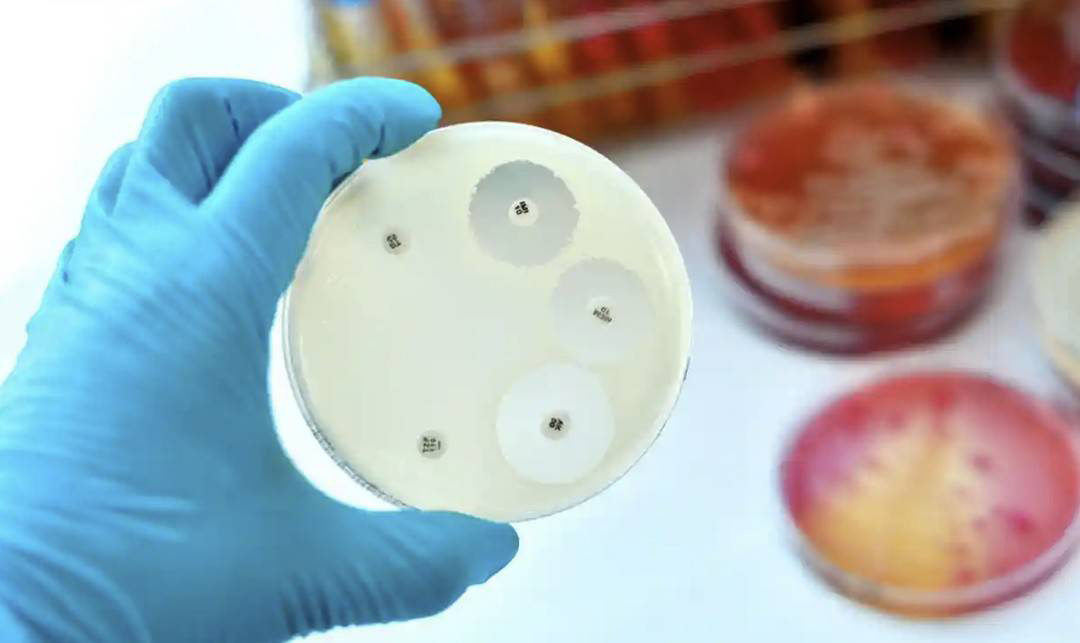

2022年,新冠疫情继续在全球肆虐和反复,但人类科技发展却未因疫情而停滞。无论是健康、能源、星空、粮食、物理、考古,科学界都在不断探索新技术、研究新领域,不断刷新人类能达到的新高度,将科学的力量应用于社会与各行各业发展,造福每一个你我。封面新闻为您盘点2022年全球科技领域取得的一些重大成就与进展,来看科技与世界革新的力量。
1
核聚变“点火”实现
人类离无限清洁能源更近一步
是否存在近乎无限的清洁能源潜在来源?过去60多年来,物理学家一直在研究核聚变技术,以期实现这一梦想,现在核聚变研究实验终于取得重大突破。12月13日,美国能源部宣布,在其国家实验室的“国家点火设施”中,首次实现了聚变反应的净能量增益:实验室的激光器向目标输入了2.05兆焦的能量,然后产生了3.15兆焦的聚变能输出。

该实验室的核聚变设施内部
核聚变反应与太阳和其他恒星释放能量的原理相同,其工作原理是:用192台激光器将氢燃料球加热到超过1亿摄氏度,并施加逾1000亿倍地球大气气压的压力,使氢原子聚变并释放能量。它与核电站目前采用的核裂变技术相反。在核裂变中,重原子分裂成较轻的原子,该过程会产生大量有辐射的废料。核聚变产生的能量更高,而且只会产生少量的放射性废料,并不会产生温室气体排放,因此不会导致气候变化。
核聚变能源如今被解锁,通往核聚变能源的未来之门正在打开。但想要核聚变能为普通家庭提供能源之前,还有一段路要走,目前主要的障碍包括降低成本和扩大能量输出的规模。
2
新冠大流行未停
疫苗研发加速推动
自从新冠病毒奥密克戎在2021年11月在非洲南部首次发现,其后迅速蔓延到全球。奥密克戎比以前的变种能更成功逃避免疫系统的防御,在2022年,出现了一群不同的奥密克戎免疫逃避分支。这也加速了针对奥密克戎的新冠疫苗研发。

新冠疫苗
2022年8月15日,英国批准了莫德纳二价疫苗用于成人新冠加强针接种,该疫苗针对新冠原始毒株以及奥密克戎变异株而开发,它既能补充免疫能力,又能扩大免疫力。针对新冠肺炎的鼻腔喷雾剂也已成为疫苗工具之一。9月,中国启动了无需打针的吸入式新冠疫苗,它可诱导黏膜免疫,并可能提供针对呼吸道病毒的长期保护,还有许多类似的疫苗正处于不同的开发阶段。
3
多年生水稻研发
解放农民劳动力
水稻每次收获后都需重新种植,这对农民而言是繁重的劳作,还会导致土壤侵蚀等环境问题。培育多年生水稻可以减轻这些负担,但要让多年生水稻足够长寿和高产却又很难。12月16日,中国云南大学胡凤益团队原创性培育出的多年生稻,登上了美国《科学》杂志2022年十大科学突破榜单。
胡凤益团队利用多年生非洲长雄野生稻与一年生亚洲栽培水稻进行种间远缘杂交培育,培育了系列多年生稻品系,审定了3个多年生稻品种,可实现“一次种植,多次收割”,在全球多年生粮食作物育种领域具有里程碑意义。

不再需要季节性补种,多年生水稻可以每年为农民节省数周的辛勤工作
截至目前,多年生稻在中国的试种推广地点已达117个,种植面积为2543亩,覆盖13个主要水稻种植省份。
4
应用人工智能
识别新型抗生素药物
在过去几年里,人工智能改变了分子生物学领域,这场革命开始于AlphaFold算法,可以快速预测蛋白质复杂的三维结构,从而有助于理解蛋白质的功能,识别药物靶点。2022年,人工智能在药物发现领域实现了突破,多个科学团队报告表示首次成功应用了人工智能来识别新型抗生素药物。
在实验室进行的抗生素敏感性测试
抗菌素耐药性是人类的重大威胁,开发能克服耐药性、补充能有效抗菌的新药是我们持续面临的挑战,而在这个领域,人工智能正开始发挥重要作用。这些研究有望为一些最可怕的病原体威胁,提供前所未有的新治疗方案。
例如中国科学院马越和他的同事,使用最初为自然语言处理开发的机器学习技术,来识别由人类肠道微生物基因组序列编码的抗菌肽。该算法识别出2349个潜在的抗菌肽序列,其中216个多肽是通过化学方法合成的,其中181个具有抑菌活性。识别的成功率令人印象深刻,没有人工智能援助,这是不可能的。
5
科幻片变成现实
首次行星防御实验成功
如果未来发现有近地小行星有可能撞击地球,人类可否有应对之计?毕竟之前有研究表明,6500万年前“希克苏鲁伯小行星撞击”事件直接导致了恐龙的灭绝。而天文学家预估一共有25000颗近地小行星大到足以摧毁一座大城市,而且常见到足以构成威胁。如今,科幻片中的剧情,在今年成为了现实。

小行星Dimorphos是今年潜在行星防御系统试运行的目标
9月26日,由NASA发射的 DART(戏称“打他”)航天器, 成功撞击距地1100万千米的一颗小行星“迪莫弗斯”(Dimorphos),并使其偏离轨道,并使其轨道周期缩短了32分钟。“迪莫弗斯”是一颗直径160米的小行星,它围绕另一颗直径达780米的小行星“迪迪莫斯”(Didymos)旋转。这是人类首次有意识地改变天体运动,全面验证了小行星偏转技术。尽管这次撞击是一次性任务,但是它为科学家们提供了关键数据参考,能为以后设计任何撞击小行星任务动量模型提供数据支撑。
6
电池快充技术进步
极速充电不是梦
电池技术的飞速发展为电气化世界打下基础,让人类可以减少对化石燃料的依赖。但疑问仍在,电池有足够的容量储存足够多电能来为飞机这样的设备提供动力吗?可以从哪里获得建造这样的电池所需要的稀有金属?成本又是如何呢?

在美国加利福尼亚州莫哈韦沙漠的布里斯托尔湖提取锂
电池的基本原理没有改变,但最新版本潜力惊人,而且一直都在变得更好。根据10月份发表在《自然》杂志上的论文,美国宾夕法尼亚州立大学王朝阳团队,首次实现高能量密度锂离子电池(265 Wh/kg)10分钟极速充电,且循环寿命高达到2000次以上。如果能在10到12分钟为汽车电池充电,那更频繁充电就不再是一个问题,从而可以制造更便宜、资源密集度更低的更小电池。
7
实验室造出迄今最冷物质
极端低温中物理学发生真正变化
已知最冷温度是多少?在日本京都的一个实验室里,来自美国和日本的科学家,在实验室内,将物质(镱原子)冷却到了仅比绝对零度(零下273.15摄氏度,即所有粒子运动都停止时的温度)高十亿分之一摄氏度,使之成为整个宇宙中最冷的物质。这项研究发表在9月的《自然·物理学》上,打开了通往未经探索的量子磁场领域的门户。

图片来源:美国莱斯大学官网
研究人员称,他们造出的冷却物质甚至比太空中已知最冷的区域——旋镖星云还要冷。旋镖星云温度约为1开尔文或零下272摄氏度,仅比绝对零度(零下273.15摄氏度)高1摄氏度。研究人员表示:冷却到这一极端低温的结果是物理学发生了真正的变化,更偏向量子力学。希望通过研究和理解它们,发现新的物理学现象。
8
“从鱼到人”怎么来的?
科学家填补进化树关键空白
生命的起源和演化一直是科学研究的重大课题之一,脊椎动物的起源和演化更是关系到人类从何而来。今年9月29日,中国科学院古脊椎动物与古人类研究所朱敏团队在《自然》上发表四篇论文,集中报道了他们对有颌类的起源与最早期辐射分化的最新研究进展,研究团队表示,所发现最古老的古鱼类化石为“奇迹秀山鱼”,正是鱼类登上陆地后,逐渐演化成人的关键证据。

中国志留纪早期(兰多维列世,约4.4亿年前)五种古鱼的三维复原
据悉,包括人类在内,地球上现存99.8%的脊椎动物都具有颔骨,统称为“有颔脊椎动物”或“有颔类”。有颌类的出现与崛起是“从鱼到人”的脊椎动物演化史上最关键的跃升之一。然而,这一跃升具体发生在何时、何地、又是如何发生?关于早期有颔类生物的演化,仍存在3500万年空白的化石纪录。
朱敏团队在重庆、贵州等地志留纪早期距今约4.4亿年的地层中,发现“重庆特异埋藏化石库”和“贵州石阡化石库”,在其中发现了全球最古老的“有颔类牙齿化石”,而发现最多的物种为“奇迹秀山鱼”,同时也是当前发现的最古老的有颔类,将完整有颔类的化石纪录向前推了1100万年。这些研究填补了“从鱼到人”演化史上缺失的最初始环节,更新了对有颌类起源与崛起的传统认知,进一步夯实了“从鱼到人”的演化路径。